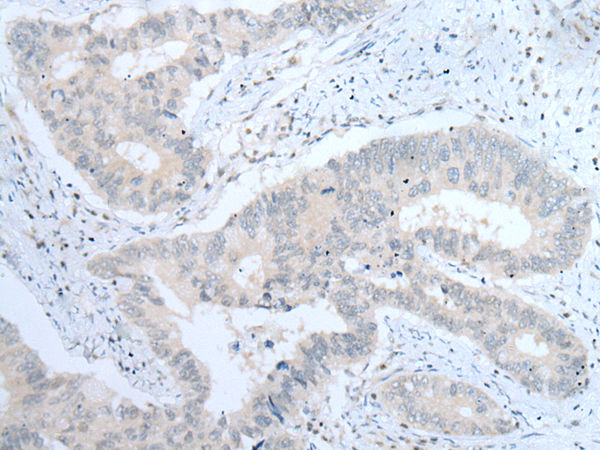
一抗

|
Background: |
Integrins are heterodimeric transmembrane receptor proteins that mediate numerous cellular processes including cell adhesion, cytoskeletal rearrangement, and activation of cell signaling pathways. Integrins are composed of alpha and beta subunits. This gene encodes the alpha 8 subunit of the heterodimeric integrin alpha8beta1 protein. The encoded protein is a single-pass type 1 membrane protein that contains multiple FG-GAP repeats. This repeat is predicted to fold into a beta propeller structure. This gene regulates the recruitment of mesenchymal cells into epithelial structures, mediates cell-cell interactions, and regulates neurite outgrowth of sensory and motor neurons. The integrin alpha8beta1 protein thus plays an important role in wound-healing and organogenesis. Mutations in this gene have been associated with renal hypodysplasia/aplasia-1 (RHDA1) and with several animal models of chronic kidney disease. Alternate splicing results in multiple transcript variants encoding distinct isoforms. |
|
Applications: |
ELISA, IHC |
|
Name of antibody: |
ITGA8 |
|
Immunogen: |
Synthetic peptide of human ITGA8 |
|
Full name: |
integrin subunit alpha 8 |
|
SwissProt: |
P53708 |
|
ELISA Recommended dilution: |
5000-10000 |
|
IHC positive control: |
Human colorectal cancer |
|
IHC Recommend dilution: |
25-100 |

 購物車
購物車 幫助
幫助
 021-54845833/15800441009
021-54845833/15800441009